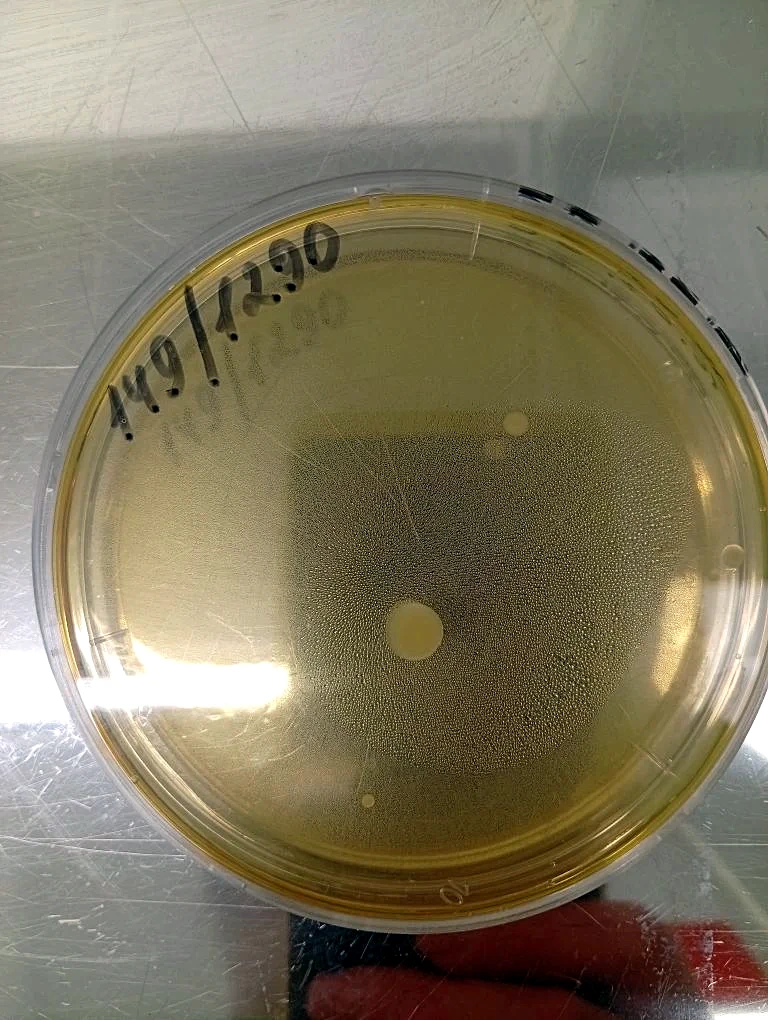

Инженером-лаборантом бактериологической лаборатории Ессентукского филиала ФБУ «Северо-Кавказский ЦСМ» Дианой Вершининой проводятся исследования проб воздуха лечебных учреждений на показатели его чистоты: общее микробное число, золотистый стафилококк, дрожжи и плесневые грибы.
Чистота воздуха в лечебных учреждениях критически важна для предотвращения внутрибольничных инфекций, обеспечения стерильности операционных и реабилитации ослабленных пациентов. В медицинских учреждениях высокая концентрация патогенов, устойчивых к дезинфекции. Пациенты с пониженным иммунитетом крайне чувствительны к ним, поэтому стерильность воздуха жизненно необходима. Чистота воздуха необходима для работы операционных, реанимаций и палат интенсивной терапии, где даже попадание микробных частиц в рану может быть смертельным.
Для обеспечения чистоты воздуха в лечебных учреждениях применяют комплекс мер: бактерицидные рециркуляторы, УФ-облучатели, высокоэффективные HEPA-фильтры, системы приточно-вытяжной вентиляции.